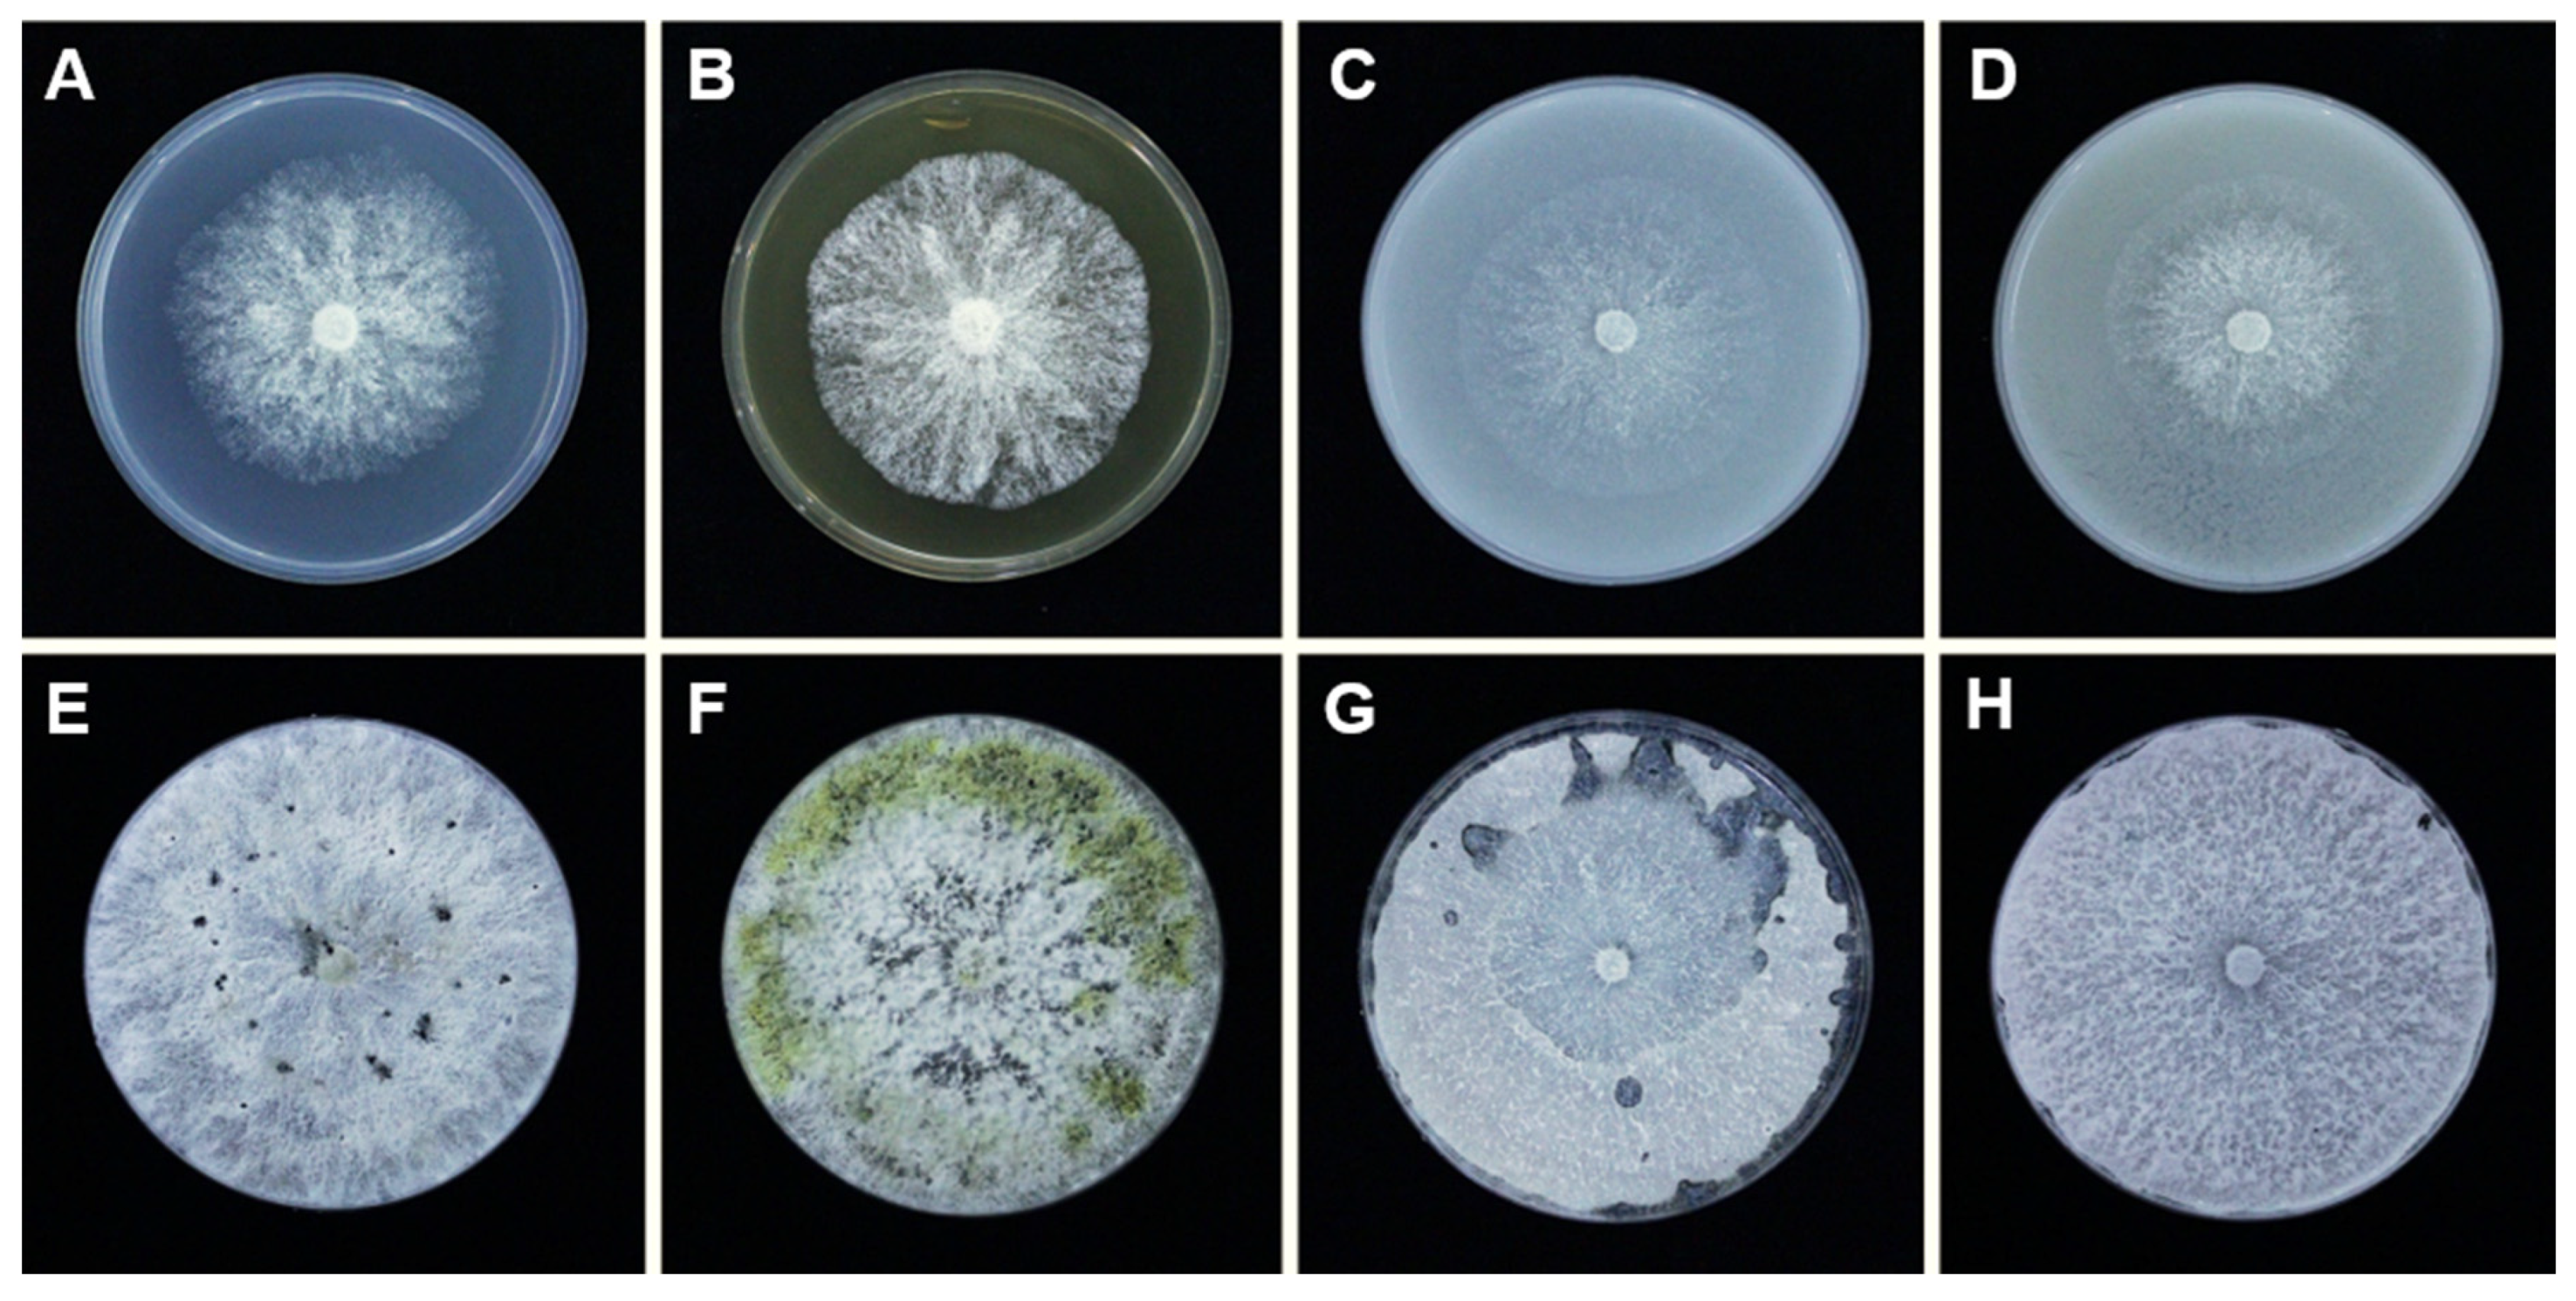
Plants 10 00218 g001 Plants 10 00218 g001

Morphology Characterization, Molecular Phylogeny, and Pathogenicity of Diaporthe passifloricola on Citrus reticulata cv. Nanfengmiju in Jiangxi Province, China
Abstract
1. Introduction
2. Results
2.1. Morphological Characterization of D. passifloricola
2.2. Pathogenicity Test
2.3. Phylogenetic Analyses
3. Discussion
4. Materials and Methods
4.1. Fungal Isolation
4.2. Morphological Characterization
4.3. Pathogenicity Test
4.4. DNA Extraction, PCR Amplification, and Sequencing
4.5. Phylogenetic Analyses
5. Conclusions
Supplementary Materials
Author Contributions
Funding
Institutional Review Board Statement
Informed Consent Statement
Data Availability Statement
Acknowledgments
Conflicts of Interest
References
- Deng, X.X.; Peng, C.J.; Chen, Z.S.; Deng, Z.N.; Xu, J.G.; Li, J. Citrus Varieties in China; China Agriculture Press: Beijing, China, 2008. [Google Scholar]
- FAO. Citrus Fruit—Fresh and Processed Statistical Bulletin 2016; Food and Agriculture Organization of the United Nations: Rome, Italy, 2017. [Google Scholar]
- Kucharek, T.; Whiteside, J.; Brown, E. Melanose and phomopsis stem-end rot of citrus. In Plant Pathology Fact Sheet; Florida Cooperative Extension Service, Institute of Food and Agricultural Sciences, University of Florida: Florida, FL, USA, 2000; pp. 26–30. [Google Scholar]
- Timmer, L.W.; Garnsey, S.M.; Graham, J.H. Scab Diseases, revised edition: 31–32 ed.; American Phytopathological Society Press: St. Paul, MN, USA, 2000; p. 92. [Google Scholar]
- Huang, F.; Hou, X.; Dewdney, M.M.; Fu, Y.S.; Chen, G.Q.; Hyde, K.D.; Li, H.Y. Diaporthe species occurring on citrus in China. Fungal Divers. 2013, 61, 237–250. [Google Scholar] [CrossRef]
- Huang, F.; Udayanga, D.; Wang, X.H.; Hou, X.; Mei, X.F.; Fu, Y.S.; Hyde, K.D.; Li, H.Y. Endophytic Diaporthe associated with Citrus: A phylogenetic reassessment with seven new species from China. Fungal Biol. 2015, 119, 331–347. [Google Scholar] [CrossRef]
- Chaisiri, C.; Liu, X.Y.; Lin, Y.; Li, J.B.; Xiong, B.; Luo, C.X. Phylogenetic analysis and development of molecular tool for detection of Diaporthe citri causing melanose disease of citrus. Plants 2020, 9, 329. [Google Scholar] [CrossRef] [PubMed]
- Bach, W.J.; Wolf, F.A. The isolation of the fungus that causes citrus melanose and the pathological anatomy of the host. J. Agric. Res. 1928, 37, 243–252. [Google Scholar]
- Gopal, K.; Lakshmi, L.M.; Sarada, G.; Nagalakshmi, T.; Sankar, T.G.; Gopi, V.; Ramana, K.T.V. Citrus melanose (Diaporthe citri Wolf): A review. Int. J. Curr. Microbiol. App. Sci. 2014, 3, 113–124. [Google Scholar]
- Fawcett, H.S. The cause of stem-end rot of citrus fruits (Phomopsis citri n. sp.). Phytopathology 1912, 2, 109–113. [Google Scholar]
- Mondal, S.N.; Vicent, A.; Reis, R.F.; Timmer, L.W. Saprophytic colonization of citrus twigs by Diaporthe citri and factors affecting pycnidial production and conidial survival. Plant. Dis. 2007, 91, 387–392. [Google Scholar] [CrossRef]
- Chen, G.Q.; Jiang, L.Y.; Xu, F.S.; Li, H.Y. In vitro and in vivo screening of fungicides for controlling citrus melanose caused by Diaporthe citri. J. Zhejiang Univ. (Agric. Life Sci.) 2010, 36, 440–444. (In Chinese) [Google Scholar]
- Jiang, L.Y.; Xu, F.S.; Huang, Z.D.; Huang, F.; Chen, G.Q.; Li, H.Y. Occurrence and control of citrus melanose caused by Diaporthe citri. Acta Agric. Zhejiangensis 2012, 24, 647–653. (In Chinese) [Google Scholar]
- Udayanga, D.; Manamgoda, D.S.; Liu, X.Z.; Chukeatirote, E.; Hyde, K.D. What are the common anthracnose pathogens of tropical fruits? Fungal Divers. 2013, 61, 165–179. [Google Scholar] [CrossRef]
- Huang, L. The diseases of Citrus spp. of Guangxi. Guangxi Nong Xun 1943, 4, 27–61. (In Chinese) [Google Scholar]
- Guangdong Station of Plant Quarantine. The preliminary investigation results of Citrus spp. insects and diseases in East Guangdong province. 1955; 1–3. (In Chinese) [Google Scholar]
- Qiu, W.F. The records of diseases and insects of economic plants in Fujian (1, 2, 3). Xin Nong Ji Kan 1941, 1, 70–75, 161–166, 209–229. (In Chinese) [Google Scholar]
- Plant quarantine Station; Department of Agriculture; Jiangxi Academy of Agriculture. The Records of Plant Insects and Diseases in Jiangxi, the Part of Plant Diseases; Jiangxi People’s Publishing House: Nanchang, China, 1960; pp. 1–247. (in Chinese) [Google Scholar]
- Li, L. The index of the parasitic fungi of Szechwan, China. Pl. Dis. Rep. Suppl. 1948, 173, 1–38. [Google Scholar]
- Chinese Research Institute of Pomelogy and Citrus. The Records of Chinese Fruit Trees’ Diseases and Pests; China Agriculture Press: Beijing, China, 1994. (In Chinese) [Google Scholar]
- Guarnaccia, V.; Groenewald, J.Z.; Woodhall, J.; Armengol, J.; Cinelli, T.; Eichmeier, A.; Ezra, D.; Fontaine, F.; Gramaje, D.; Gutierrez-Aguirregabiria, A.; et al. Diaporthe diversity and pathogenicity revealed from a broad survey of grapevine diseases in Europe. Persoonia 2018, 40, 135–153. [Google Scholar] [CrossRef] [PubMed]
- Santos, J.M.; Phillips, A.J.L. Resolving the complex of Diaporthe (Phomopsis) species occurring on Foeniculum vulgare in Portugal. Fungal Divers. 2009, 34, 111–125. [Google Scholar]
- Thompson, S.M.; Tan, Y.P.; Shivas, R.G.; Neate, S.M.; Morin, L.; Bissett, A.; Aitken, E.A.B. Green and brown bridges between weeds and crops reveal novel Diaporthe species in Australia. Persoonia 2015, 35, 39–49. [Google Scholar] [CrossRef]
- Udayanga, D.; Castlebury, L.A.; Rossman, A.Y.; Chukeatirote, E.; Hyde, K.D. Insights into the genus Diaporthe: Phylogenetic species delimitation in the D. eres species complex. Fungal Divers. 2014, 67, 203–229. [Google Scholar] [CrossRef]
- Guarnaccia, V.; Crous, P.W. Emerging citrus diseases in Europe caused by species of Diaporthe. Ima Fungus 2017, 8, 317–334. [Google Scholar] [CrossRef]
- Mostert, L.; Crous, P.W.; Kang, J.C.; Phillips, A.J.L. Species of Phomopsis and a Libertella sp. occurring on grapevines with specific reference to South Africa: Morphological, cultural, molecular and pathological characterization. Mycologia 2001, 93, 146–167. [Google Scholar] [CrossRef]
- Rehner, S.A.; Uecker, F.A. Nuclear ribosomal internal transcribed spacer phylogeny and host diversity in the coelomycete Phomopsis. Can. J. Bot. 1994, 72, 1666–1674. [Google Scholar] [CrossRef]
- Chi, P.K.; Jiang, Z.D.; Xiang, M.M. Flora Fungorum Sinicorum; Science Press: Beijing, China, 2007; Volume 34. (In Chinese) [Google Scholar]
- Dissanayake, A.J.; Zhang, W.; Liu, M.; Hyde, K.D.; Zhao, W.S.; Li, X.H.; Yan, J.Y. Diaporthe species associated with peach tree dieback in Hubei, China. Mycosphere 2017, 8, 533–549. [Google Scholar] [CrossRef]
- Gao, Y.H.; Liu, F.; Duan, W.J.; Crous, P.W.; Cai, L. Diaporthe is paraphyletic. Ima Fungus 2017, 8, 153–187. [Google Scholar] [CrossRef] [PubMed]
- Yang, Q.; Fan, X.L.; Guarnaccia, V.; Tian, C.M. High diversity of Diaporthe species associated with dieback diseases in China, with twelve new species described. MycoKeys 2018, 39, 97–149. [Google Scholar] [CrossRef] [PubMed]
- Fan, X.L.; Yang, Q.; Bezerra, J.D.P.; Alvarez, L.V.; Tian, C.M. Diaporthe from walnut tree (Juglans regia) in China, with insight of the Diaporthe eres complex. Mycol. Prog. 2018, 17, 841–853. [Google Scholar] [CrossRef]
- Guo, Y.S.; Crous, P.W.; Bai, Q.; Fu, M.; Yang, M.M.; Wang, X.H.; Du, Y.M.; Hong, N.; Xu, W.X.; Wang, G.P. High diversity of Diaporthe species associated with pear shoot canker in China. Persoonia 2020, 45, 132–162. [Google Scholar] [CrossRef]
- Wehmeyer, L.E. The genus Diaporthe Nitschke and its segregates. Univ. Mich. Stud. Sci. Ser. 1933, 9, 1–349. [Google Scholar]
- Sutton, B.C. The Coelomycetes. Fungi Imperfecti with Pycnidia, Acervuli and Stromata; Commonwealth Mycological Institute: London, UK, 1980. [Google Scholar]
- Rosskopf, E.N.; Charudattan, R.; Shabana, Y.M.; Benny, G.L. Phomopsis amaranthicola, a new species from amaranthus sp. Mycologia 2000, 92, 114–122. [Google Scholar] [CrossRef]
- Gomes, R.R.; Glienke, C.; Videira, S.I.R.; Lombard, L.; Groenewald, J.Z.; Crous, P.W. Diaporthe: A genus of endophytic, saprobic and plant pathogenic fungi. Persoonia 2013, 31, 1–41. [Google Scholar] [CrossRef]
- Santos, L.; Alves, A.; Alves, R. Evaluating multi-locus phylogenies for species boundaries determination in the genus Diaporthe. PeerJ 2017, 5, 1–26. [Google Scholar] [CrossRef]
- Crous, P.W.; Wingfield, M.J.; Richardson, D.M.; Le Roux, J.J.; Strasberg, D.; Edwards, J.; Roets, F.; Hubka, V.; Taylor, P.W.J.; Heykoop, M.; et al. Fungal planet description sheets: 400–468. Persoonia 2016, 36, 316–458. [Google Scholar] [CrossRef]
- Crous, P.W.; Wingfield, M.J.; Chooi, Y.H.; Gilchrist, C.L.M.; Lacey, E.; Pitt, J.I.; Roets, F.; Swart, W.J.; Cano-Lira, J.F.; Valenzuela-Lopez, N.; et al. Fungal planet description sheets: 1042–1111. Persoonia 2020, 44, 301–459. [Google Scholar] [CrossRef] [PubMed]
- Wanasinghe, D.N.; Phukhamsakda, C.; Hyde, K.D.; Jeewon, R.; Lee, H.B.; Jones, E.B.G.; Tibpromma, S.; Tennakoon, D.S.; Dissanayake, A.J.; Jayasiri, S.C.; et al. Fungal diversity notes 709–839: Taxonomic and phylogenetic contributions to fungal taxa with an emphasis on fungi on Rosaceae. Fungal Divers. 2018, 89, 1–60. [Google Scholar] [CrossRef]
- Udayanga, D.; Castlebury, L.A.; Rossman, A.Y.; Chukeatirote, E.; Hyde, K.D. The Diaporthe sojae species complex: Phylogenetic re-assessment of pathogens associated with soybean, cucurbits and other field crops. Fungal Biol. 2015, 119, 383–407. [Google Scholar] [CrossRef] [PubMed]
- Farr, D.F.; Castlebury, L.A.; Rossman, A.Y.; Putnam, M.L. A new species of Phomopsis causing twig dieback of Vaccinium vitis-idaea (lingonberry). Mycol. Res. 2002, 106, 745–752. [Google Scholar] [CrossRef]
- Santos, J.M.; Correia, V.G.; Phillips, A.J.L.; Spatafora, J.W. Primers for mating-type diagnosis in Diaporthe and Phomopsis: Their use in teleomorph induction in vitro and biological species definition. Fungal Biol. 2010, 114, 255–270. [Google Scholar] [CrossRef] [PubMed]
- Udayanga, D.; Liu, X.Z.; Crous, P.W.; McKenzie, E.H.C.; Chukeatirote, E.; Hyde, K.D. A multi-locus phylogenetic evaluation of Diaporthe (Phomopsis). Fungal Divers. 2012, 56, 157–171. [Google Scholar] [CrossRef]
- Uecker, F.A. A world list of Phomopsis names with notes on nomenclature, morphology and biology. Mycol. Mem. 1988, 13, 1–231. [Google Scholar]
- Brayford, D. Variation in Phomopsis isolates from Ulmus species in the British Isles and Italy. Mycol. Res. 1990, 94, 691–697. [Google Scholar] [CrossRef]
- van Niekerk, J.M.; Groenewald, J.Z.; Farr, D.F.; Fourie, P.H.; Halleen, F.; Crous, P.W. Reassessment of Phomopsis species on grapevine. Australas. Plant. Pathol. 2005, 34, 27–39. [Google Scholar] [CrossRef]
- Rossman, A.Y.; Adams, G.C.; Cannon, P.F.; Castlebury, L.A.; Crous, P.W.; Gryzenhout, M.; Jaklitsch, W.M.; Mejia, L.C.; Stoykov, D.; Udayanga, D.; et al. Recommendations of generic names in Diaporthales competing for protection or use. Ima Fungus 2015, 6, 145–154. [Google Scholar] [CrossRef]
- Dissanayake, A.J.; Phillips, A.J.L.; Hyde, K.D.; Yan, J.Y.; Li, X.H. The current status of species in Diaporthe. Mycosphere 2017, 8, 1106–1156. [Google Scholar] [CrossRef]
- Udayanga, D.; Castlebury, L.A.; Rossman, A.Y.; Hyde, K.D. Species limits in Diaporthe: Molecular re-assessment of D. citri, D. cytosporella, D. foeniculina and D. rudis. Persoonia 2014, 32, 83–101. [Google Scholar] [CrossRef] [PubMed]
- Guarnaccia, V.; Crous, P.W. Species of Diaporthe on Camellia and Citrus in the Azores Islands. Phytopathol. Mediterr. 2018, 57, 307–319. [Google Scholar]
- Douanla-Meli, C.; Langer, E.; Mouafo, F.T. Fungal endophyte diversity and community patterns in healthy and yellowing leaves of Citrus limon. Fungal Ecol. 2013, 6, 212–222. [Google Scholar] [CrossRef]
- Murali, T.S.; Suryanarayanan, T.S.; Geeta, R. Endophytic Phomopsis species: Host range and implications for diversity estimates. Can. J. Microbiol. 2006, 52, 673–680. [Google Scholar] [CrossRef] [PubMed]
- Petrini, O. Fungal endophytes of tree leaves. In Microbial Ecology of Leaves; Andrews, J.H., Hirano, S.S., Eds.; Brock/Springer Series in Contemporary Bioscience; Springer: New York, NY, USA, 1991; pp. 179–197. [Google Scholar]
- Raimondo, M.L.; Carlucci, A. Characterization and pathogenicity of Plectosphaerella spp. collected from basil and parsley in Italy. Phytopathol. Mediterr. 2018, 57, 284–295. [Google Scholar]
- Raimondo, M.L.; Carlucci, A. Characterisation and pathogenicity assessment of Plectosphaerella species associated with stunting disease on tomato and pepper crops in Italy. Plant. Pathol. 2018, 67, 626–641. [Google Scholar] [CrossRef]
- Takemoto, D.; Tanaka, A.; Kayano, Y.; Saikia, S.; Wrenn, R.; Scott, B. Reactive oxygen as a signal in grass-Epichloë symbiosis. In Epichloae, Endophytes of Cool Season Grasses: Implications, Utilization and Biology. Proceedings of the 7th International Symposium on Fungal Endophytes of Grasses; Young, C.A., Aiken, G.E., McCullry, R.L., Strickland, J.R., Schardl, C.L., Eds.; Samuel Roberts Noble Foundation: Lexington, KY, USA, 2012; pp. 109–112. [Google Scholar]
- Fisher, P.J.; Petrini, O. Fungal saprobes and pathogens as endophytes of rice (Oryza sativa L.). New Phytol. 1992, 120, 137–143. [Google Scholar] [CrossRef]
- Akai, S. Histology of defense in plants. In Plant Pathology; Horsfall, J.G., Dimond, A.E., Eds.; Academic Press: New York, NY, USA, 1959; Volume 1, pp. 435–467. [Google Scholar]
- Arimoto, Y.; Homma, Y.; Misato, T. Studies on citrus melanose and citrus stem-end rot by Diaporthe citri (Faw.) Wolf. Part 2. Infection mode of D. citri to citrus leaf. Ann. Phytopath. Soc. Jpn. 1980, 46, 575–581. [Google Scholar] [CrossRef]
- Arimoto, Y.; Homma, Y.; Misato, T. Studies on citrus melanose and citrus stem-end rot by Diaporthe citri (Faw.) Wolf. Part 3. Leaf against infection of D. citri. Ann. Phytopath. Soc. Jpn. 1982, 48, 559–569. [Google Scholar] [CrossRef]
- Yin, L.F.; Chen, S.N.; Chen, G.K.; Schnabel, G.; Du, S.F.; Chen, C.; Li, G.Q.; Luo, C.X. Identification and characterization of three Monilinia species from plum in China. Plant. Dis. 2015, 99, 1775–1783. [Google Scholar] [CrossRef] [PubMed][Green Version]
- Rayner, R.W. A Mycological Colour Chart; Commonwealth Mycological Institute and British Mycological Society: Kew, Surrey, UK, 1970. [Google Scholar]
- Kanematsu, S.; Kobayashi, T.; Kudo, A.; Ohtsu, Y. Conidial morphology, pathogenicity and culture characteristics of Phomopsis isolates from peach, Japanese pear and apple in Japan. Jpn J. Phytopathol. 1999, 65, 264–273. [Google Scholar] [CrossRef]
- Hu, M.J.; Cox, K.D.; Schnabel, G.; Luo, C.X. Monilinia species causing brown rot of peach in China. PLoS ONE 2011, 6, e24990. [Google Scholar] [CrossRef] [PubMed]
- White, T.J.; Bruns, T.; Lee, S.; Taylor, J. Amplification and direct sequencing of fungal ribosomal RNA genes for phylogenetics. In PCR Protocols: A Guide to Methods and Applications; Innis, M.A., Gelfand, D.H., Sninsky, J.J., White, T.J., Eds.; Academic Press: San Diego, CA, USA, 1990; pp. 315–322. [Google Scholar]
- Glass, N.L.; Donaldson, G.C. Development of primer sets designed for use with the PCR to amplify conserved genes from filamentous ascomycetes. Appl. Environ. Microb. 1995, 61, 1323–1330. [Google Scholar] [CrossRef] [PubMed]
- Carbone, I.; Kohn, L.M. A method for desianing primer sets for speciation studies in filamentous ascomycetes. Mycologia 1999, 91, 553–556. [Google Scholar] [CrossRef]
- Crous, P.W.; Groenewald, J.Z.; Risède, J.M.; Simoneau, P.; Hywel-Jones, N.L. Calonectria species and their Cylindrocladium anamorphs: Species with clavate vesicles. Stud. Mycol. 2004, 50, 415–430. [Google Scholar] [CrossRef] [PubMed]
- Katoh, K.; Rozewicki, J.; Yamada, K.D. MAFFT online service: Multiple sequence alignment, interactive sequence choice and visualization. Brief. Bioinform. 2017, bbx108, 1–7. [Google Scholar] [CrossRef] [PubMed]
- Hall, A.T. BioEdit: A user-friendly biological sequence alignment editor and analysis program for windows 95/98/nt. Nucleic Acids Res. 1999, 41, 95–98. [Google Scholar]
- Stamatakis, A. RAxML version 8: A tool for phylogenetic analysis and post-analysis of large phylogenies. Bioinformatics 2014, 30, 1312–1313. [Google Scholar] [CrossRef]
- Miller, M.A.; Pfeiffer, W.; Schwartz, T. The CIPRES science gateway: A community resource for phylogenetic analyses. In TeraGrid Conference: Extreme Digital Discovery; San Diego Supercomputer Center: San Diego, CA, USA, 2011; Volume 41, pp. 1–8. [Google Scholar]
- Swofford, D.L. PAUP* Phylogenetic Analysis Using Parsimony, (*and Other Methods). Version 4.0 b10; Sinauer Associates: Sunderland, MA, USA, 2003. [Google Scholar]
- Nylander, J.A.A. MrModeltest v.2. Program Distributed by the Author; Evolitionary Biology Centre, Uppsala Univeristy: Uppsala, Sweden, 2004. [Google Scholar]
- Crous, P.W.; Wingfield, M.J.; Schumacher, R.K.; Summerell, B.A.; Giraldo, A.; Gené, J.; Guarro, J.; Wanasinghe, D.N.; Hyde, K.D.; Camporesi, E.; et al. Fungal planet description sheets: 281–319. Persoonia 2014, 33, 212–289. [Google Scholar] [CrossRef]
- Dissanayake, A.J.; Camporesi, E.; Hyde, K.D.; Zhang, W.; Yan, J.Y.; Li, X.H. Molecular phylogenetic analysis reveals seven new Diaporthe species from Italy. Mycosphere 2017, 8, 853–877. [Google Scholar] [CrossRef]
- Gao, Y.H.; Liu, F.; Cai, L. Unravelling Diaporthe species associated with Camellia. Syst. Biodivers. 2016, 14, 102–117. [Google Scholar] [CrossRef]
- Tan, Y.P.; Edwards, J.; Grice, K.R.E.; Shivas, R.G. Molecular phylogenetic analysis reveals six new species of Diaporthe from Australia. Fungal Divers. 2013, 61, 251–260. [Google Scholar] [CrossRef]
- Chang, C.Q.; Xi, P.G.; Xiang, M.M.; Jiang, Z.D.; Chi, P.K. New species of Phomopsis on woody plants in Hunan province. Mycosystema 2005, 24, 145–154. [Google Scholar]
- Mapook, A.; Hyde, K.D.; McKenzie, E.H.C.; Jones, E.B.G.; Bhat, D.J.; Jeewon, R.; Stadler, M.; Samarakoon, M.C.; Malaithing, M.; Tanunchai, B.; et al. Taxonomic and phylogenetic contributions to fungi associated with the invasive weed Chromolaena odorata (siam weed). Fungal Divers. 2020, 101, 1–175. [Google Scholar] [CrossRef]
- Souza, A.R.C.; Baldoni, D.B.; Lima, J.; Porto, V.; Marcuz, C.; Machado, C.; Ferraz, R.C.; Kuhn, R.C.; Jacques, R.J.S.; Guedes, J.V.C.; et al. Selection, isolation, and identification of fungi for bioherbicide production. Braz. J. Microbiol. 2017, 48, 101–108. [Google Scholar] [CrossRef]
- Crous, P.W.; Carnegie, A.J.; Wingfield, M.J.; Sharma, R.; Mughini, G.; Noordeloos, M.E.; Santini, A.; Shouche, Y.S.; Bezerra, J.D.P.; Dima, B.; et al. Fungal planet description sheets: 868–950. Persoonia 2019, 42, 291–473. [Google Scholar] [CrossRef]
- Chang, C.Q.; Cheng, Y.H.; Xiang, M.M.; Jiang, Z.D.; Chi, P.K. New species of Phomopsis in woody plants in Fujian provice. Mycosystema 2005, 24, 6–11. [Google Scholar]
- Thompson, S.M.; Tan, Y.P.; Young, A.J.; Neate, S.M.; Aitken, E.A.B.; Shivas, R.G. Stem cankers on sunflower (Helianthus annuus) in Australia reveal a complex of pathogenic Diaporthe (Phomopsis) species. Persoonia 2011, 27, 80–89. [Google Scholar] [CrossRef]
- Dissanayake, A.J.; Chen, Y.Y.; Liu, J.K. Unravelling Diaporthe species associated with woody hosts from Karst Formations (Guizhou) in China. J. Fungi 2020, 6, 251. [Google Scholar] [CrossRef]
- Manawasighe, I.S.; Dissanayake, A.J.; Li, X.H.; Liu, M.; Wanasinghe, D.N.; Xu, J.P.; Zhao, W.S.; Zhang, W.; Zhou, Y.Y.; Hyde, K.D.; et al. High genetic diversity and species complexity of Diaporthe associated with grapevine dieback in China. Front. Microbiol. 2019, 10, 1936. [Google Scholar] [CrossRef] [PubMed]
- Crous, P.W.; Summerell, B.A.; Swart, L.; Denman, S.; Taylor, J.E.; Bezuidenhout, C.M.; Palm, M.E.; Marincowitz, S.; Groenewald, J.Z. Fungal pathogens of Proteaceae. Persoonia 2011, 27, 20–45. [Google Scholar] [CrossRef] [PubMed]
- Santos, L.; Phillips, A.J.L.; Crous, P.W.; Alves, A. Diaporthe species on Rosaceae with descriptions of D. pyracanthae sp. nov. and D. malorum sp. nov. Mycosphere 2017, 8, 485–511. [Google Scholar] [CrossRef]
- Milagres, C.A.; Belisário, R.; Silva, M.A.; Lisboa, D.O.; Pinho, D.B.; Furtado, G.Q. A novel species of Diaporthe causing leaf spot in Pachira glabra. Trop. Plant. Pathol. 2018, 43, 460–467. [Google Scholar] [CrossRef]
- Crous, P.W.; Summerell, B.A.; Shivas, R.G.; Burgess, T.I.; Decock, C.A.; Dreyer, L.L.; Granke, L.L.; Guest, D.I.; Hardy, G.E.S.J.; Hausbeck, M.K.; et al. Fungal planet description sheets: 107–127. Persoonia 2012, 28, 138–182. [Google Scholar] [CrossRef]
- Marin-Felix, Y.; Hernández-Restrepo, M.; Wingfield, M.J.; Akulov, A.; Carnegie, A.J.; Cheewangkoon, R.; Gramaje, D.; Groenewald, J.Z.; Guarnaccia, V.; Halleen, F.; et al. Genera of phytopathogenic fungi: GOPHY 2. Stud. Mycol. 2019, 92, 47–133. [Google Scholar] [CrossRef]
- Gao, Y.H.; Su, Y.Y.; Sun, W.; Cai, L. Diaporthe species occurring on Lithocarpus glabra in China, with descriptions of five new species. Fungal Biol. 2015, 119, 295–309. [Google Scholar] [CrossRef]
- Yang, Q.; Du, Z.; Tian, C.M. Phylogeny and morphology reveal two new species of Diaporthe from traditional chinese medicine in Northeast China. Phytotaxa 2018, 336, 159–170. [Google Scholar] [CrossRef]
- Feng, X.X.; Chen, J.J.; Wang, G.R.; Cao, T.T.; Zheng, Y.L.; Zhang, C.L. Diaporthe sinensis, a new fungus from Amaranthus sp. in China. Phytotaxa 2019, 425, 259–268. [Google Scholar] [CrossRef]
- Sommer, N.F.; Beraha, L. Diaporthe actinidiae, a new species causing stem-end rot of chinese gooseberry fruits. Mycologia 1975, 67, 650–653. [Google Scholar] [CrossRef]
- Hyde, K.D.; Chaiwan, N.; Norphanphoun, C.; Boonmee, S.; Camporesi, E.; Chethana, K.W.T.; Dayarathne, M.C.; de Silva, N.I.; Dissanayake, A.J.; Ekanayaka, A.H.; et al. Mycosphere notes 169–224. Mycosphere 2018, 9, 271–430. [Google Scholar] [CrossRef]
- Doilom, M.; Dissanayake, A.J.; Wanasinghe, D.N.; Boonmee, S.; Liu, J.K.; Bhat, D.J.; Taylor, J.E.; Bahkali, A.H.; McKenzie, E.H.C.; Hyde, K.D. Microfungi on Tectona grandis (teak) in Northern Thailand. Fungal Divers. 2016, 82, 107–182. [Google Scholar] [CrossRef]
- Liu, J.K.; Hyde, K.D.; Jones, E.B.G.; Ariyawansa, H.A.; Bhat, D.J.; Boonmee, S.; Maharachchikumbura, S.S.N.; McKenzie, E.H.C.; Phookamsak, R.; Phukhamsakda, C.; et al. Fungal diversity notes 1–110: Taxonomic and phylogenetic contributions to fungal species. Fungal Divers. 2015, 72, 1–197. [Google Scholar] [CrossRef]
- Crous, P.W.; Wingfield, M.J.; Roux, J.J.L.; Richardson, D.M.; Strasberg, D.; Shivas, R.G.; Alvarado, P.; Edwards, J.; Moreno, G.; Sharma, R.; et al. Fungal planet description sheets: 371–399. Persoonia 2015, 35, 264–327. [Google Scholar] [CrossRef] [PubMed]
- Noriler, S.A.; Savi, D.C.; Ponomareva, L.V.; Rodrigues, R.; Rohr, J.; Thorson, J.S.; Glienke, C.; Shaaban, K.A. Vochysiamides a and b: Two new bioactive carboxamides produced by the new species Diaporthe vochysiae. Fitoterapia 2019, 138, 104273. [Google Scholar] [CrossRef] [PubMed]

| Diaporthe Species | Culture No. | Host Species | Origin | GenBank No. | Reference(s) | ||||
|---|---|---|---|---|---|---|---|---|---|
| ITS | TUB | TEF | HIS | CAL | |||||
| D. acaciarum | CBS 138862 | Acacia tortilis | Tanzania | KP004460 | KP004509 | – | KP004504 | – | [77] |
| D. acericola | MFLUCC 17-0956 | Acer negundo | Italy | KY964224 | KY964074 | KY964180 | – | KY964137 | [78] |
| D. alangii | CFCC 52556 | Alangium kurzii | China | MH121491 | MH121573 | MH121533 | MH121451 | MH121415 | [31] |
| D. amaranthophila | ATCC 74226 | Amaranthus sp. | USA | AF079776 | – | – | – | – | [36] |
| D. ambigua | CBS 114015 | Pyrus communis | South Africa | KC343010 | KC343978 | KC343736 | KC343494 | KC343252 | [37] |
| D. angelicae | CBS 111592 | Heracleum sphondylium | Austria | KC343027 | KC343995 | KC343753 | KC343511 | KC343269 | [37] |
| D. apiculatum | CGMCC3.17533 | Camellia sinensis | China | KP267896 | KP293476 | KP267970 | – | – | [79] |
| D. arctii | CBS 136.25 | Arctium sp. | Unknown | KC343031 | KC343999 | KC343757 | KC343515 | KC343273 | [37] |
| D. batatas | CBS 122.21 | Ipomoea batatas | USA | KC343040 | KC344008 | KC343766 | KC343524 | KC343282 | [37] |
| D. beilharziae | VPRI 16602 | Indigofera australis | Australia | JX862529 | KF170921 | JX862535 | – | – | [80] |
| D. caryae | CFCC 52563 | Carya illinoensis | China | MH121498 | MH121580 | MH121540 | MH121458 | MH121422 | [31] |
| D. chimonanthi | SCHM 3614 | Chimonanthus praecox | China | AY622993 | – | – | – | – | [81] |
| D. chromolaenae | MFLUCC 17-1422 | Chromolaena odorata | Thailand | MT214362 | – | – | – | – | [82] |
| D. cichorii | MFLUCC 17-1023 | Cichorium intybus | Italy | KY964220 | KY964104 | KY964176 | – | KY964133 | [78] |
| D. citri | CBS 135422 | Citrus sp. | USA | KC843311 | KC843187 | KC843071 | MF418281 | KC843157 | [25,51] |
| D. compacta | CGMCC3.17536 | Camellia sinensis | China | KP267854 | KP293434 | KP267928 | KP293508 | – | [79] |
| D. convolvuli | CBS 124654 | Convolvulus arvensis | Turkey | KC343054 | KC344022 | KC343780 | KC343538 | KC343296 | [37] |
| D. cucurbitae | DAOM 42078 | Cucumis sativus | Canada | KM453210 | KP118848 | KM453211 | KM453212 | – | [42] |
| D. cuppatea | CBS 117499 | Aspalathus linearis | South Africa | KC343057 | KC344025 | KC343783 | KC343541 | KC343299 | [37] |
| D. diachenii | PH10-1 | Unknown | Lithuania | KR870866 | – | – | – | – | [83] |
| D. durionigena | VTCC 930005 | Durio zibethinus | Vietnam | MN453530 | MT276159 | MT276157 | – | – | [40] |
| D. durionigena | KCSR1906.7 | Durio zibethinus | Vietnam | MN453531 | MT276160 | MT276158 | – | – | [40] |
| D. endophytica | CBS 133811 | Schinus terebinthifolius | Brazil | KC343065 | KC344033 | KC343791 | KC343549 | KC343307 | [37] |
| D. fructicola | MAFF 246408 | Passiflora edulis x P. edulis f. flavicarpa | Japan | LC342734 | LC342736 | LC342735 | LC342737 | LC342738 | [84] |
| D. fructicola | MAFF 246409 | Passiflora edulis x P. edulis f. flavicarpa | Japan | LC342739 | LC342741 | LC342740 | LC342742 | LC342743 | [84] |
| D. ganjae | CBS 180.91 | Cannabis sativa | USA | KC343112 | KC344080 | KC343838 | KC343596 | KC343354 | [37] |
| D. glabrae | SCHM 3622 | Bougainvillea glabra | China | AY601918 | – | – | – | – | [85] |
| D. goulteri | BRIP 55657a | Helianthus annuus | Australia | KJ197289 | KJ197270 | KJ197252 | – | – | [23] |
| D. gulyae | BRIP 54025 | Helianthus annuus | Australia | JF431299 | KJ197271 | JN645803 | – | – | [23,86] |
| D. guttulata | CGMCC3.20100 | Unknown | China | MT385950 | MT424705 | MT424685 | MW022491 | MW022470 | [87] |
| D. helianthi | CBS 592.81 | Helianthus annuus | Serbia | KC343115 | KC344083 | KC343841 | KC343599 | KC343357 | [37] |
| D. hordei | CBS 481.92 | Hordeum vulgare | Norway | KC343120 | KC344088 | KC343846 | KC343604 | KC343362 | [37] |
| D. hubeiensis | JZB320123 | Vertis vinifera | China | MK335809 | MK500147 | MK523570 | – | MK500235 | [88] |
| D. infecunda | CBS 133812 | Schinus terebinthifolius | Brazil | KC343126 | KC344094 | KC343852 | KC343610 | KC343368 | [37] |
| D. infertilis | CBS 230.52 | Citrus sinensis | Suriname | KC343052 | KC344020 | KC343778 | KC343536 | KC343294 | [37] |
| D. kongii | BRIP 54031 | Helianthus annuus | Australia | JF431301 | KJ197272 | JN645797 | – | – | [23,86] |
| D. leucospermi | CBS 111980 | Leucospermum sp. | Australia | JN712460 | – | – | – | – | [89] |
| D. longicolla | ATCC 60325 | Glycine max | USA | KJ590728 | KJ610883 | KJ590767 | KJ659188 | KJ612124 | [42] |
| D. longicolla | CBS 127267 | Glycine max | Croatia | KC343199 | KC344167 | KC343925 | KC343683 | KC343441 | [42] |
| D. longicolla | CBS 116023 | Glycine max | USA | KC343198 | KC344166 | KC343924 | KC343682 | KC343440 | [42] |
| D. longispora | CBS 194.36 | Ribes sp. | Canada | KC343135 | KC344103 | KC343861 | KC343619 | KC343377 | [37] |
| D. lusitanicae | CBS 123212 | Foeniculum vulgare | Portugal | KC343136 | KC344104 | KC343862 | KC343620 | KC343378 | [37] |
| D. malorum | CBS 142383 | Malus domestica | Portugal | KY435638 | KY435668 | KY435627 | KY435648 | KY435658 | [90] |
| D. manihotia | CBS 505.76 | Manihot utilissima | Rwanda | KC343138 | KC344106 | KC343864 | KC343622 | KC343380 | [37] |
| D. masirevicii | BRIP 57892a | Helianthus annuus | Australia | KJ197277 | KJ197257 | KJ197239 | – | – | [23] |
| D. megalospora | CBS 143.27 | Sambucus canadensis | Unknown | KC343140 | KC344108 | KC343866 | KC343624 | KC343382 | [37] |
| D. melonis | CBS 507.78 | Cucumis melo | USA | KC343142 | KC344110 | KC343868 | KC343626 | KC343384 | [37] |
| D. michelina | SCHM 3603 | Michelia alba | China | AY620820 | – | – | – | – | [30] |
| D. middletonii | BRIP 54884e | Rapistrum rugostrum | Australia | KJ197286 | KJ197266 | KJ197248 | – | – | [23] |
| D. minusculata | CGMCC3.20098 | Unknown | China | MT385957 | MT424712 | MT424692 | MW022499 | MW022475 | [87] |
| D. miriciae | BRIP 54736j | Helianthus annuus | Australia | KJ197282 | KJ197262 | KJ197244 | – | – | [23] |
| D. miriciae | BRIP 55662c | Glycine max | Australia | KJ197283 | KJ197263 | KJ197245 | – | – | [23] |
| D. miriciae | BRIP 56918a | Vigna radiata | Australia | KJ197284 | KJ197264 | KJ197246 | – | – | [23] |
| D. neoarctii | CBS 109490 | Ambrosia trifida | USA | KC343145 | KC344113 | KC343871 | KC343629 | KC343387 | [37] |
| D. novem | CBS 127270 | Glycine max | Croatia | KC343156 | KC344124 | KC343882 | KC343640 | KC343398 | [37] |
| D. ovalispora | CGMCC3.17256 | Citrus limon | China | KJ490628 | KJ490449 | KJ490507 | KJ490570 | – | [6] |
| D. pachirae | COAD2074 | Pachira glabra | Brazil | MG559537 | MG559541 | MG559539 | – | MG559535 | [91] |
| D. passiflorae | CBS 132527 | Passiflora edulis | South America | JX069860 | KY435674 | KY435633 | KY435654 | KY435664 | [92] |
| D. passifloricola | CBS 141329 | Passiflora foetida | Malaysia | KX228292 | KX228387 | – | KX228367 | – | [39] |
| D. passifloricola | NFIF-3-11 | Citrus reticulata cv. Nanfengmiju | China | MG786598 | MG925398 | MG925401 | MK238998 | MK238995 | This study |
| D. passifloricola | NFIF-3-19 | Citrus reticulata cv. Nanfengmiju | China | MG786599 | MG925399 | MG925402 | MK238999 | MK238996 | This study |
| D. passifloricola | NFIF-3-21 | Citrus reticulata cv. Nanfengmiju | China | MG786600 | MG925400 | MG925403 | MK239000 | MK238997 | This study |
| D. phaseolorum | CBS 139281 | Phaseolus vulgaris | USA | KJ590738 | KJ610893 | KJ590739 | KJ659220 | KJ612135 | [42] |
| D. pyracanthae | CBS 142384 | Pyracantha coccinea | Portugal | KY435635 | KY435666 | KY435625 | KY435645 | KY435656 | [90] |
| D. racemosae | CBS 143770 | Euclea racemosa | South Africa | MG600223 | MG600227 | MG600225 | MG600221 | MG600219 | [93] |
| D. rosae | MFLUCC 17-2658 | Rosa sp. | Thailand | MG828894 | MG843878 | – | – | MG829273 | [41] |
| D. rosae | MFLUCC 18-0354 | Magnolia champaca | Thailand | MG906792 | MG968951 | MG968953 | – | – | [94] |
| D. rosae | MFLUCC 17-2574 | Senna siamea | Thailand | MG906793 | MG968952 | MG968954 | – | – | [94] |
| D. sackstonii | BRIP 54669b | Helianthus annuus | Australia | KJ197287 | KJ197267 | KJ197249 | – | – | [23] |
| D. salicicola | VPRI 32789 | Salix purpurea | Australia | JX862531 | KF170923 | JX862537 | – | – | [80] |
| D. sambucusii | CFCC 51986 | Sambucus williamsii | China | KY852495 | KY852511 | KY852507 | KY852503 | KY852499 | [95] |
| D. schini | CBS 133181 | Schinus terebinthifolius | Brazil | KC343191 | KC344159 | KC343917 | KC343675 | KC343433 | [37] |
| D. schoeni | MFLUCC 17-2930 | Schoenus nigricans | Italy | KY964226 | KY964109 | KY964182 | – | KY964139 | [78] |
| D. sclerotioides | CBS 296.67 | Cucumis sativus | Netherlands | KC343193 | KC344161 | KC343919 | KC343677 | KC343435 | [37] |
| D. serafiniae | BRIP 55665a | Helianthus annuus | Australia | KJ197274 | KJ197254 | KJ197236 | – | – | [23] |
| D. sinensis | CGMCC3.19521 | Amaranthus sp. | China | MK637451 | MK660447 | MK660449 | MK660451 | – | [96] |
| D. sojae | CBS 139282 | Glycine max | USA | KJ590719 | KJ610875 | KJ590762 | KJ659208 | KJ612116 | [42] |
| D. sojae (D. actinidiae) | ICMP13683 | Actinidia deliciosa | New Zealand | KC145886 | – | KC145941 | – | – | [97] |
| D. sojae (D. camptothecae) | SCHM 3611 | Camptotheca acuminate | China | AY622996 | – | – | – | – | [81] |
| D. sojae (D. kochmanii) | BRIP 54033 | Helianthus annuus | Australia | JF431295 | – | JN645809 | – | – | [42,86] |
| D. sojae (D. melonis var. brevistylospora) | MAFF 410444 | Cucumis melo | Japan | KJ590714 | KJ610870 | KJ590757 | KJ659203 | KJ612111 | [42] |
| D. stewartii | CBS 193.36 | Cosmos bipinnatus | Unknown | FJ889448 | JX275421 | GQ250324 | – | JX197415 | [44,45] |
| D. subellipicola | KUMCC 17-0153 | Unknown | China | MG746632 | MG746634 | MG746633 | – | – | [98] |
| D. subordinaria | CBS 101711 | Plantago lanceolata | New Zealand | KC343213 | KC344181 | KC343939 | KC343697 | KC343455 | [37] |
| D. tecomae | CBS 100547 | Tabebuia sp. | Brazil | KC343215 | KC344183 | KC343941 | KC343699 | KC343457 | [37] |
| D. tectonae | MFLUCC 12-0777 | Tectona grandis | Thailand | KU712430 | KU743977 | KU749359 | – | KU749345 | [99] |
| D. tectonendophytica | MFLUCC 13-0471 | Tectona grandis | Thailand | KU712439 | KU743986 | KU749367 | – | KU749354 | [99] |
| D. terebinthifolii | CBS 133180 | Schinus terebinthifolius | Brazil | KC343216 | KC344184 | KC343942 | KC343700 | KC343458 | [37] |
| D. thunbergiicola | MFLUCC 12-0033 | Thunbergia laurifolia | Thailand | KP715097 | – | KP715098 | – | – | [100] |
| D. tulliensis | BRIP 62248a | Theobroma cacao | Australia | KR936130 | KR936132 | KR936133 | – | – | [101] |
| D. ueckerae | CBS 139283 | Cucumis melo | USA | KJ590726 | KJ610881 | KJ590747 | KJ659215 | KJ612122 | [42] |
| D. ueckerae | FAU659 | Cucumis melo | USA | KJ590724 | KJ610879 | KJ590745 | KJ659213 | KJ612120 | [42] |
| D. ueckerae | FAU658 | Cucumis melo | USA | KJ590725 | KJ610880 | KJ590746 | KJ659214 | KJ612119 | [42] |
| D. ueckerae | FAU660 | Cucumis melo | USA | KJ590723 | KJ610878 | KJ590744 | KJ659212 | KJ612121 | [42] |
| D. unshiuensis | CGMCC3.17569 | Citrus unshiu | China | KJ490587 | KJ490408 | KJ490466 | KJ490529 | – | [6] |
| D. unshiuensis | ZJUD51 | Fortunella margarita (Lour.) Swingle | China | KJ490586 | KJ490407 | KJ490465 | KJ490528 | – | [6] |
| D. unshiuensis | ZJUD50 | Fortunella margarita (Lour.) Swingle | China | KJ490585 | KJ490406 | KJ490464 | KJ490527 | – | [6] |
| D. vexans | CBS 127.14 | Solanum melongena | USA | KC343229 | KC344197 | KC343955 | KC343713 | KC343471 | [37] |
| D. vitimegaspora | STE-U2675 | Vitis vinifera | Taiwan | AF230749 | – | – | – | – | [26] |
| D. vochysiae | LGMF1583 | Vochysia divergens | Brazil | MG976391 | MK007527 | MK007526 | MK033323 | MK007528 | [102] |
| Diaporthe sp. 1 | CBS 119639 | Man, abscess | Germany | KC343202 | KC344170 | KC343928 | KC343686 | KC343444 | [37] |
| Diaporthella corylina | CBS 121124 | Corylus sp. | China | KC343004 | KC343972 | KC343730 | KC343488 | KC343246 | [37] |
Publisher’s Note: MDPI stays neutral with regard to jurisdictional claims in published maps and institutional affiliations. |
© 2021 by the authors. Licensee MDPI, Basel, Switzerland. This article is an open access article distributed under the terms and conditions of the Creative Commons Attribution (CC BY) license (http://creativecommons.org/licenses/by/4.0/).
Share and Cite
Chaisiri, C.; Liu, X.-Y.; Yin, W.-X.; Luo, C.-X.; Lin, Y. Morphology Characterization, Molecular Phylogeny, and Pathogenicity of Diaporthe passifloricola on Citrus reticulata cv. Nanfengmiju in Jiangxi Province, China. Plants 2021, 10, 218. https://doi.org/10.3390/plants10020218
Chaisiri C, Liu X-Y, Yin W-X, Luo C-X, Lin Y. Morphology Characterization, Molecular Phylogeny, and Pathogenicity of Diaporthe passifloricola on Citrus reticulata cv. Nanfengmiju in Jiangxi Province, China. Plants. 2021; 10(2):218. https://doi.org/10.3390/plants10020218
Chicago/Turabian StyleChaisiri, Chingchai, Xiang-Yu Liu, Wei-Xiao Yin, Chao-Xi Luo, and Yang Lin. 2021. "Morphology Characterization, Molecular Phylogeny, and Pathogenicity of Diaporthe passifloricola on Citrus reticulata cv. Nanfengmiju in Jiangxi Province, China" Plants 10, no. 2: 218. https://doi.org/10.3390/plants10020218
APA StyleChaisiri, C., Liu, X.-Y., Yin, W.-X., Luo, C.-X., & Lin, Y. (2021). Morphology Characterization, Molecular Phylogeny, and Pathogenicity of Diaporthe passifloricola on Citrus reticulata cv. Nanfengmiju in Jiangxi Province, China. Plants, 10(2), 218. https://doi.org/10.3390/plants10020218

